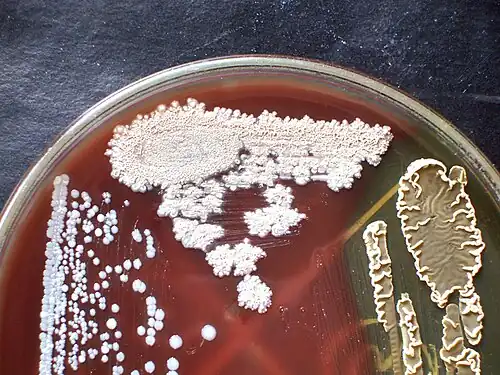

Портал:Микробиология и иммунология
Микробиология и иммунология![]() ![]() Микробиология — наука в составе биологии, занимающаяся изучением микроорганизмов (бактерии, архебактерии, микроскопические грибы и водоросли, часто этот список продляют простейшими и вирусами). В область интересов микробиологии входит их систематика, морфология, физиология, биохимия, эволюция, роль в экосистемах а также возможности практического использования. Разделом микробиологии является бактериология. Иммуноло́гия — наука об иммунитете живых организмов, изучающая биологические механизмы самозащиты организма от любых чужеродных веществ. Иммунология исследует закономерности строения и функционирования иммунной системы, её заболевания, ищет способы иммунотерапии. Избранная статья![]() Мимивирус — род вирусов, включающий в себя единственный опознанный вид Acanthamoeba polyphaga mimivirus (APMV). В обиходе APMV обычно называют просто мимивирусом. Данный вирус отличается наибольшим диаметром капсида из всех известных вирусов, а также, по сравнению с другими вирусами, более объёмным (более 1,2 миллионов п.н.) и сложноструктурированным геномом. В свете нехватки точных данных о природе данного вируса, его открытие вызвало большой интерес в научных кругах. Было высказано предположение, что мимивирус представляет собой недостающее звено между вирусами и бактериями. Более радикальное мнение говорит о том, что мимивирус представляет собой принципиально новую форму жизни, не относящуюся к вирусам или бактериям. Избранное изображение![]() Колонии бактерий рода Bacillus на кровяном агаре
Знаете ли вы, что…
Как я могу помочьВ этом разделе Вы можете оставлять запросы на статьи о микробиологии: Запросы на новые статьи:
Запросы на улучшение статей:
Перевод статейС английского: Оценка статьи
Микробиология в интернетеhttp://www.nobel-prize.ru/med_mikrobiologia.html http://www.asm.org/index.asp American society for microbiology http://www.microbiology.ru/ Актибиотики и антимикробная терапия http://www.microbiol.org/ The Microbiology Network http://pathmicro.med.sc.edu/book/welcome.htm Microbiology and Immunology On-line http://microbewiki.kenyon.edu/index.php/MicrobeWiki MicrobeWiki, the student-edited microbiology resource Избранная личностьАндре́ Мише́ль Львов (фр. André Michel Lwoff, 8 мая 1902, Энэ-лё-Шато — 30 сентября 1994, Париж) — французский микробиолог, лауреат Нобелевской премии по физиологии и медицине в 1965 году (совместно с Франсуа Жакобом и Жаком Моно) «за открытия, касающиеся генетического контроля синтеза ферментов и вирусов». В возрасте 19 лет поступил в Пастеровский институт, где учился у всемирно известного французского микробиолога Эдуара Шатона (фр. Edouard Chatton), с которым впоследствии работал вместе в течение 17 лет. Первые исследования Львова были в области паразитических инфузорий, цикла их развития и морфогенеза. Позднее работал над проблемами, связанными с питанием простейших одноклеточных организмов. В 1962 предложил классификацию вирусов. Ввёл понятие провируса; работы по механизму заражения провирусами бактерий были удостоены Нобелевской премии. В 1932—1933 по гранту Рокфеллеровского фонда работал в лаборатории Отто Мейергофа в Гейдельберге. В 1936 году по другому гранту того же фонда работал в Кембридже в лаборатории Дэвида Кейлина. В 1938 году Львов становится деканом факультета в Пастеровском институте, а в 1959 профессором микробиологии на Факультете наук в Париже. Андре Львов имел почётные степени ряда университетов: Чикагского (D. Sc., 1959), Оксфордского (D. Sc., 1959), Глазго (Doctor of Laws, 1963) и Лувени (M. D., 1966). Новые статьиСписок новых статей по иммунологии и микробиологии (обновляется автоматически ботом ClaymoreBot).
Категории
СтатьиРазделы микробиологииАнтимикробные препаратыАнтимикробные препараты
Проекты |